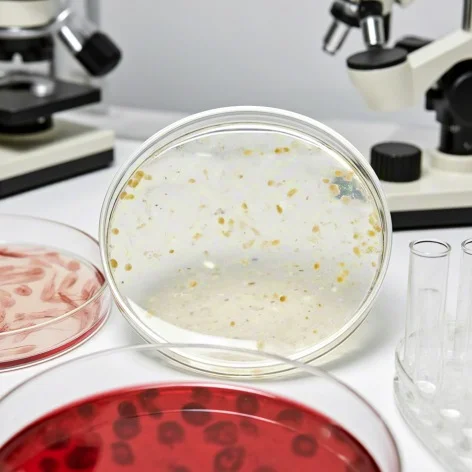
细胞粘附实验

一、实验类型与原理
静态细胞粘附实验
原理:在无外力作用下,量化细胞与基质(或细胞间)的静态结合能力。
应用场景:评估药物对细胞粘附的影响、筛选基质材料、研究胚胎发育中的组织分隔。
示例:将乳腺癌细胞接种于纤连蛋白包被的96孔板,通过结晶紫染色后酶标仪检测吸光度,量化粘附细胞数量。
流动细胞粘附实验
原理:通过可控流体剪切力模拟生理环境(如血管血流),研究细胞动态粘附行为。
应用场景:分析白细胞滚动粘附、血管内皮细胞行为、人工血管材料评估。
示例:在流动腔中以50rpm恒温摇荡培养人脐静脉内皮细胞,3小时后用钙黄绿素-AM检测贴壁细胞荧光强度。
细胞-细胞粘附实验
原理:量化细胞间结合能力,评估药物干预或基因修饰对粘附特性的影响。
典型流程:
将未标记细胞铺于多孔板形成单层基底;
加入荧光标记的待测细胞共孵育;
洗涤后通过残留荧光强度与粘附细胞数量正相关测定相互作用强度。
二、关键操作步骤
基质包被
材料选择:常用胶原蛋白、纤连蛋白、层粘连蛋白,浓度需预实验优化(如纤连蛋白10μg/250μl)。
操作要点:4℃过夜包被后,PBS洗涤3次去除未结合蛋白,1% BSA封闭未包被区域以减少非特异性粘附。
细胞接种与培养
密度控制:根据细胞类型调整(如293T细胞1-4×10⁴个/孔),设置3个复孔以减少误差。
孵育时间:静态实验通常15-60分钟,需通过时间梯度预实验确定最佳粘附时间。
洗涤与固定
洗涤力度:PBS轻柔洗涤3次,避免细胞脱落(可将枪头尖端剪掉一小节以减少液体冲击)。
固定方法:4%多聚甲醛室温固定15分钟,增强细胞结构稳定性。
染色与检测
结晶紫染色:0.1%结晶紫室温染色30分钟,PBS洗涤后加入裂解液(0.5% Triton X-100或2% SDS),酶标仪检测595nm(Triton X-100)或550nm(SDS)吸光度。
荧光检测:钙黄绿素-AM标记活细胞,荧光显微镜或酶标仪检测Ex/Em=494/517nm荧光强度,计算粘附率=(贴壁细胞荧光值/总接种细胞荧光值)×100%。
#医学实验 #医院医生科研实验外包 #细胞实验 #医学检验 #科研日常
静态细胞粘附实验
原理:在无外力作用下,量化细胞与基质(或细胞间)的静态结合能力。
应用场景:评估药物对细胞粘附的影响、筛选基质材料、研究胚胎发育中的组织分隔。
示例:将乳腺癌细胞接种于纤连蛋白包被的96孔板,通过结晶紫染色后酶标仪检测吸光度,量化粘附细胞数量。
流动细胞粘附实验
原理:通过可控流体剪切力模拟生理环境(如血管血流),研究细胞动态粘附行为。
应用场景:分析白细胞滚动粘附、血管内皮细胞行为、人工血管材料评估。
示例:在流动腔中以50rpm恒温摇荡培养人脐静脉内皮细胞,3小时后用钙黄绿素-AM检测贴壁细胞荧光强度。
细胞-细胞粘附实验
原理:量化细胞间结合能力,评估药物干预或基因修饰对粘附特性的影响。
典型流程:
将未标记细胞铺于多孔板形成单层基底;
加入荧光标记的待测细胞共孵育;
洗涤后通过残留荧光强度与粘附细胞数量正相关测定相互作用强度。
二、关键操作步骤
基质包被
材料选择:常用胶原蛋白、纤连蛋白、层粘连蛋白,浓度需预实验优化(如纤连蛋白10μg/250μl)。
操作要点:4℃过夜包被后,PBS洗涤3次去除未结合蛋白,1% BSA封闭未包被区域以减少非特异性粘附。
细胞接种与培养
密度控制:根据细胞类型调整(如293T细胞1-4×10⁴个/孔),设置3个复孔以减少误差。
孵育时间:静态实验通常15-60分钟,需通过时间梯度预实验确定最佳粘附时间。
洗涤与固定
洗涤力度:PBS轻柔洗涤3次,避免细胞脱落(可将枪头尖端剪掉一小节以减少液体冲击)。
固定方法:4%多聚甲醛室温固定15分钟,增强细胞结构稳定性。
染色与检测
结晶紫染色:0.1%结晶紫室温染色30分钟,PBS洗涤后加入裂解液(0.5% Triton X-100或2% SDS),酶标仪检测595nm(Triton X-100)或550nm(SDS)吸光度。
荧光检测:钙黄绿素-AM标记活细胞,荧光显微镜或酶标仪检测Ex/Em=494/517nm荧光强度,计算粘附率=(贴壁细胞荧光值/总接种细胞荧光值)×100%。
#医学实验 #医院医生科研实验外包 #细胞实验 #医学检验 #科研日常